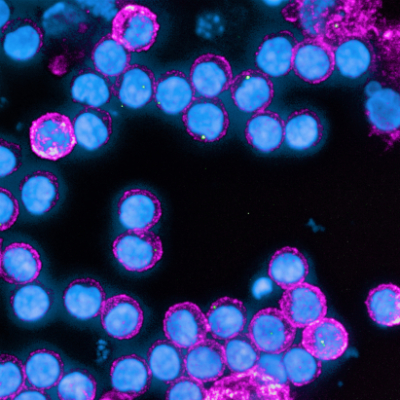

Neue Studie: Überraschende Erkenntnis zur Immunantwort älterer Covid-19 Genesener
Antikörper bleiben auch bei Älteren lern- und abwehrfähig
Ältere Menschen erkranken oft schwerer an COVID-19 als Jüngere, müssen häufiger intensivmedizinisch betreut werden und haben ein höheres Sterberisiko. Nach überstandener SARS-CoV-2 Infektion zeigen Ältere jedoch eine überraschend robuste Immunantwort, die sich an der Bindungsstärke ihrer Antikörper ablesen lässt.
Pressebilder zum Download:
BU li: Fluoreszenzmikroskopische Aufnahme menschlicher Lymphozyten. Einige von diesen, sogenannte B-Lymphozyten, können Antikörper produzieren. Als „memory cells“ sind sie in der Lage, die Information über die exakte Bauweise ihrer dann hochaviden Antikörper sogar viele Jahrzehnte abzuspeichern und bei einer erneuten Infektion wieder „abzurufen“ © D. Wilflingseder.
BU re: Reinhard Würzner vom Innsbrucker Institut für Hygiene und Medizinische Mikrobiologie liefert unerwartete Erkenntnisse zur Schutzfunktion der SARS-CoV-2 spezifischen Antikörper bei älteren Menschen. © MUI/Bullock
Innsbruck, am 10.06.2021: Eine durchgemachte SARS-CoV-2 Infektion bietet einen guten Schutz vor einer weiteren Erkrankung. Die vom Immunsystem gebildeten Antikörper bleiben auch Monate nach der Infektion stabil. Das haben Antikörper-Studien wie etwa jene des Instituts für Virologie der Medizin Uni Innsbruck in der Gemeinde Ischgl gezeigt. Bislang wurde jedoch angenommen, dass die Bindungsstärke (Avidität) und damit die Abwehrkraft dieser Antikörper bei älteren Menschen weniger stark ansteigt und sie deshalb nicht so gut und nachhaltig gegen eine erneute Infektion gewappnet sind wie Jüngere.
Eine neue, soeben im Journal of Infectious Diseases veröffentlichte Studie der Medizinischen Universität Innsbruck unter der Leitung von Reinhard Würzner (Institut für Hygiene und Medizinische Mikrobiologie) liefert nun unerwartete Erkenntnisse zur Schutzfunktion der SARS-CoV-2 spezifischen Antikörper bei älteren Menschen. „Wir konnten zeigen, dass ältere Menschen, die COVID-19 überstanden haben, eine sehr gute Immunantwort zeigen, die mehr als ein halbes Jahr nach der Infektion deutlich gereift und nicht schlechter ist, als jene von jungen Menschen“, berichtet der Medizinische Mikrobiologe Reinhard Würzner, der die Untersuchung mit seinem Team in Zusammenarbeit mit Wegene Borena und weiteren Kolleg:innen vom Institut für Virologie durchführte. Die Forscher:innen griffen dafür auf Blutproben von 217 Proband:innen aus der Ischgl-Kohorte zurück, die im Rahmen der ersten Antikörperstudie in Ischgl sero-positiv getestet worden waren.
Alters- und geschlechtsunabhängige Immunantwort
Die nach einer Infektion gebildeten Antikörper durchlaufen einen Reifungsprozess, dessen Status mittels Aviditätsmessung*) bestimmt werden kann. Allgemein gilt: Je länger eine Infektion zurückliegt, desto höher ist die Avidität der Antikörper, weil B-Lymphozyten dem Erreger immer exakter angepasstere, also mit hoher Bindungsstärke ausgestattete Antikörper bilden. „In unserer Studie stieg die Avidität der SARS-CoV-2 spezifischen Antikörper nicht nur bei den Jüngeren, sondern überraschenderweise in fast gleichem Maße auch bei Älteren an“, so Würzner. Lag die Avidität ein bis sechs Wochen nach Infektion in allen Altersgruppen bei durchschnittlich 18 Prozent, stieg dieser Wert sechs Monaten später in allen Altersgruppen auf über 42 Prozent. Auch bei Betrachtung einzelner Altersgruppen ließ sich eine altersunabhängige Steigerung festmachen. „Eine gewisse Limitation dieser Studie besteht natürlich darin, dass die untersuchten Proben von Genesenen stammen, also Personen, die die Infektion überstanden haben“, betont Würzner.
Nachdem Daten aus zahlreichen Studien zeigen, dass Männer schwerer an COVID-19 erkranken und auch eher an der Infektion versterben, analysierten die Innsbrucker Forscher:innen zudem, ob sich geschlechtsspezifische Unterschiede bei der Schutzkapazität der Antikörper feststellen lassen. Das Ergebnis: Die Avidität der Antikörper lag auch sieben bis acht Monate nach Infektion bei beiden Geschlechtern auf gleichem Niveau.
Für Würzner lässt die Studie auch Rückschlüsse auf den relativ guten Impfschutz Älterer zu: „Ich denke, dass unsere Ergebnisse auch die Generierung funktionell guter Antikörper bei Älteren nach einer Impfung erklären. Viele Impfungen sind ja bei Älteren deutlich weniger wirksam, aber bei den COVID-19 Impfungen war dies bisher nicht besonders auffällig“, so Würzner.
Avidität als kostengünstiger Ersatzmarker
Eine Validierung der Ergebnisse erfolgte mittels Neutralisationstest. Dieses teure und aufwändige Testverfahren, bei dem für den Nachweis neutralisierender Antikörper ein lebendes Virus eingesetzt wird, galt bislang als alternativlos in der Qualitätskontrolle. „In unserer Studie bestätigte der Neutralisationstest, dass eine hohe Avidität mit neutralisierender Antikörperkapazität, also hohem Infektionsschutz korreliert. Damit erweist sich die Messung der Avidität als effektives und günstiges diagnostisches Mittel, mit dem es möglich wird, kostspielige Neutralisationstests zu ersetzen und den Antikörpernachweis zu optimieren“, schließt Würzner.
Steckbrief:
Reinhard Würzner ist Facharzt für Hygiene und Mikrobiologie und Facharzt für Labormedizin. Seine Expertise liegt in der Erforschung von Komplement, einem Teil des angeborenen Abwehrsystems. An der Medizinischen Universität Innsbruck koordiniert er die internationalen Doktoratskollegs HOROS und CORVOS, die sich auf die Bekämpfung von Infektionen fokussieren.
*) Avididtätsmessung: Tests zur Messung der Avidität (funktionelle Affinität) von Antikörpern haben das Ziel, frische von kürzlich abgelaufenen Infektionen mit Hilfe nur einer serologischen Untersuchung trennen zu können. Dabei wird Harnsäure eingesetzt, die nur leichte, aber nicht starke Antigen-Antikörperbindungen trennen kann. Die Avidität der spezifischen Antikörper steigt im Laufe von etwa 6 bis 12 Monaten nach einer Infektion auf ihr Maximum, und kann sogar 100% erreichen. Besonders Fälle von Infektionen mit positiven IgM-Antikörpern, die ja auch sensitiv frische Infektionen anzeigen, sind für eine Überprüfung im Aviditätstest prädestiniert, um durch die Unterscheidung von niedriger Avidität von hoher, frische von kürzlich abgelaufenen oder latenten Infektionen trennen zu können. Die Aviditätsmessung hat in der Labordiagnostik schwangerschaftsrelevanter Virusinfektionen besondere Bedeutung, etwa im Zusammenhang mit Röteln-Viren. Bei niedriger Avidität ist die Infektion frisch, das Ungeborene ist also gefährdet. Umgekehrt sind jedoch viele Neugeborene trotz eines positiven IgMs gesund einer Interruptio entgangen, eben weil die Avidität der Antikörper hoch war und man so die Infektion vor dem Beginn der Schwangerschaft wahrscheinlich machen konnte.
Forschungsarbeit: Marked increase in avidity of Severe Acute Respiratory Syndrome Coronavirus 2(SARS-CoV-2) antibodies 7-8 months after infection is not diminished in old age
PR & Medien
Für Rückfragen:
ao.Univ.-Prof. Dr.med. Reinhard Würzner, PhD
Institut für Hygiene und Medizinische Mikrobiologie
Tel.: +43 512 9003 70707
E-Mail: Reinhard.Wuerzner@i-med.ac.at
Medienkontakt:
Doris Heidegger
Öffentlichkeitsarbeit Medizinische Universität Innsbruck
Innrain 52, 6020 Innsbruck, Austria
Telefon: +43 512 9003 70083, Mobil: +43 676 8716 72083
public-relations@i-med.ac.at, www.i-med.ac.at